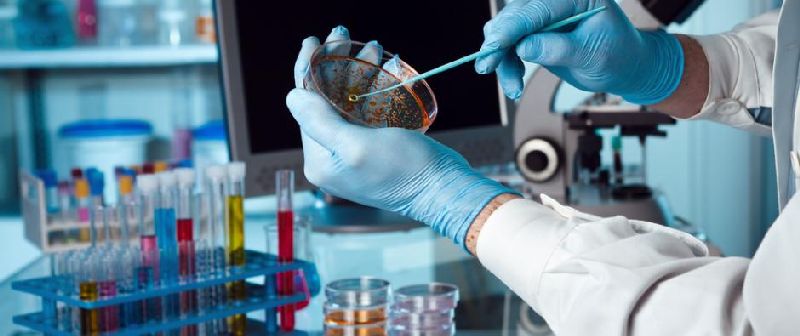
konferans

GİMDES Laboratuvar Analizlerinde Kasım – Ocak (2019-2020) Ayları Raporu
Elif ELMA l GİMDES Laboratuvar Hizmetleri Sorumlusu – Kimya Mühendisi
GİMDES Laboratuvar çalışmaları rutin olarak işlemektedir. Raporların yayınlanması hem üretici firmalar için kontrolünü hem de helal güvence sistemi ile yürütülen çalışmaların şeffaflığını tüketicilere sunmayı sağlamaktadır. GİMDES dosyalarında tutulan raporlardan kasım, aralık ve ocak ayları için yaptırılan ürünlere ait bilgiler mevcuttur.
Son 3 ayda yaptırılan analizleri özet olarak incelersek,
70 adet ürün için 133 adet analiz yaptırılmıştır. Bu çalışmalar istatistiksel verileri ortaya koymak için çıkarılmıştır. 8 numunenin sonucu uygun değil olarak tespit edilmiştir. Bir numunede pestisit tespit edilmiştir. ARGE olarak çalışılan bir numunede ve başka bir hammadde de ise sığır dnası tespit edilmiştir. Bir numunede melamin sonucu limit değerin üstünde tespit edilmiştir. Bir numunede benzoik asit tespit edilmiştir. Bir numunede ise ağır metal sonucu limit değerlerin üstünde tespit edilmiştir. Bir hammaddede etil alkol tespit edilmiştir. Başka bir numunede de patulin sonucu limit değerlerin üstünde tespit edilmiştir. Sonuçlara göre, sertifika için yeni müracaat eden, kapsam genişletme talebinde bulunan ilgili firmalara gerekli bildirimler yapılmış ve düzeltici / önleyici faaliyetler alınmıştır.
En doğrusunu Allah bilir.
Ürünlerinde analiz yapılan Firmalar;
Afia Gıda, Ak Nişasta, Aygören Süt, Baharium Baharat, Bakkalbaşı Süt, Balsu Fındık, Beşan Nişasta Bolvadin Süt, Diversey, Doğa Makarna, Erpiliç , Estuz, Faber Kimya, Gimdes – Arge, Golda Gıda, Gül Marka, Güneyce Pazarlama, Hurmacınız, İzi Süt, Kadooğlu Yağ, Kervan Süt, Meykon, Nelly Gıda, Nihoruz Un, Onaylar Yeşil Mersin, Osmanlı Un, Ova Süt, Önem Gıda, Sabırlar Fındık, Sayınlar Gıda, Sunar Elita Yağ, Sunar Mısır, Tarım Kredi Süt, Taşkesti Su, Tatşen , Tekirdağ Un, Toru Un, Unsan Un (Osmanlı), Volsa Gıda, Yarkim, Yeşil Marka, Zeyko Tarım